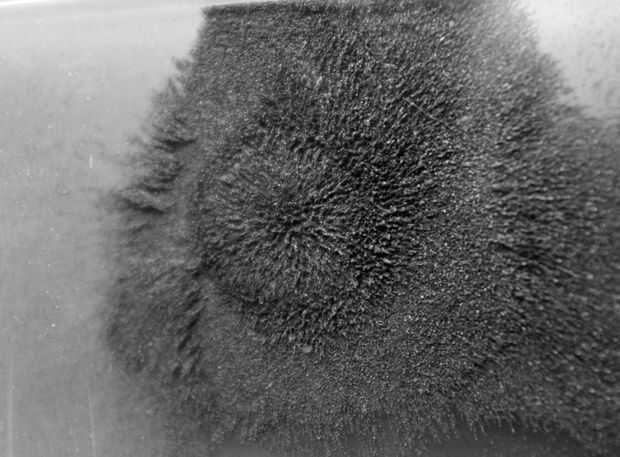

Paso 11: Altavoces convencionales

Se puede ver este principio en el trabajo en un altavoz convencional, dinámico.
La bobina de alambre (bobina) se ajusta en una ranura circular, los lados que son magnéticos. El anillo exterior es un polo. Media (poste pieza) es el otro polo. Los campos magnéticos (flechas azules) pase a través de la bobina (flechas verdes). El resultado: la bobina empuja hacia fuera (flechas rojas), perpendicular al cono.
Hora de diseñar su propio:
Piense en el papel como un palillo golpear un tambor cabeza--desea el cable para mover perpendicular a la superficie de papel y alambre.
El papel sirve como del altavoz diafragma. Cuando el cable vibra el papel, el papel mueve las moléculas de aire, con resultados audibles.